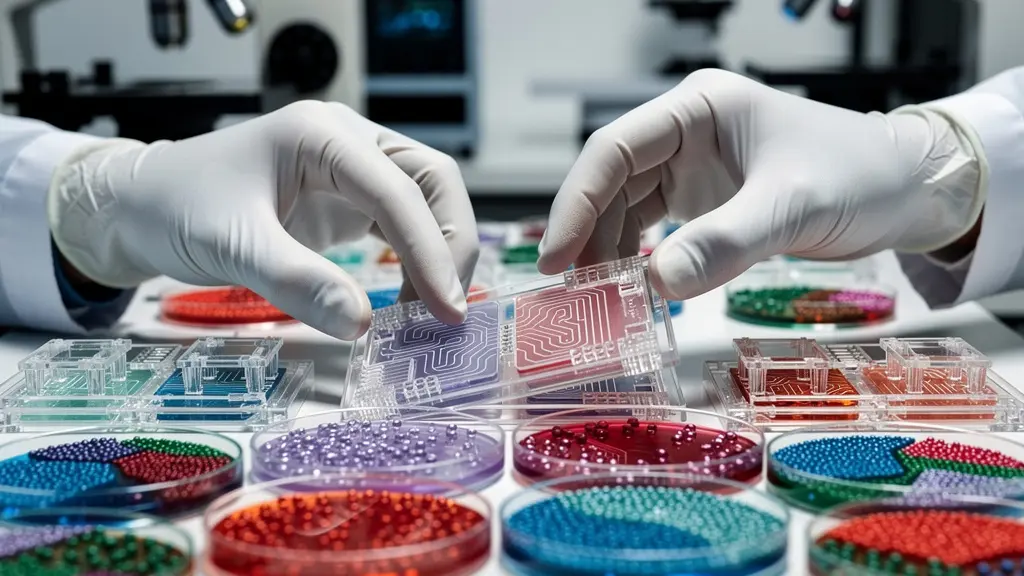
Moderne Forschungsmethoden wie Organ-on-a-Chip-Systeme als Alternative zu Tierversuchen, die das 3R-Prinzip symbolisieren.

Die Geschwindigkeit, mit der ein Krebsmedikament in der Schweiz den Patienten erreicht, ist kein linearer Sprint, sondern das Resultat eines hochgradig vernetzten Ökosystems, in dem strategische Entscheidungen den Weg bestimmen.
- Exzellente klinische Infrastruktur in Universitätsspitälern ermöglicht effiziente Phase-III-Studien, den finalen Test vor der Zulassung.
- Frühe, strategische Patentierung und die Wahl des richtigen Forschungsumfelds (Startup vs. Konzern) sind entscheidende Weichenstellungen.
- Ein dichtes Netz aus akademischer Spitzenforschung (ETH, Unis), Finanzierungsquellen (SNF, Risikokapital) und Industrie-Clustern schafft einen einzigartigen Nährboden.
Empfehlung: Für Patienten und Investoren ist das Verständnis dieser Ökosystem-Logik – anstelle eines starren Zeitplans – entscheidend, um den wahren Wert und die realistische Verfügbarkeit einer neuen Therapie einschätzen zu können.
Die Frage, wie schnell ein vielversprechendes Molekül aus einem Basler Labor zu einem zugelassenen Krebsmedikament wird, beschäftigt Patienten, Angehörige und Investoren gleichermassen. Die Standardantwort verweist oft auf einen langen und kostspieligen Prozess, der sich über mehr als ein Jahrzehnt erstrecken kann. Man spricht von präklinischer Forschung, den klinischen Phasen I, II und III und schliesslich der behördlichen Hürde durch Swissmedic. Weltweit beträgt die mediane Entwicklungszeit für neue Krebsmedikamente 11,1 Jahre von der Patentanmeldung bis zur Markteinführung.
Diese lineare Betrachtung greift jedoch für die Schweiz zu kurz. Der Weg von der Forschung zum Patienten ist hier weniger eine starre Pipeline als vielmehr ein dynamisches und hochgradig vernetztes Ökosystem. Es ist ein Geflecht aus akademischer Exzellenz, gezielter staatlicher Förderung, unternehmerischem Wagemut in Startups und der geballten Kraft globaler Pharmakonzerne. Jeder Schritt ist eine strategische Weichenstellung, die den gesamten weiteren Verlauf beeinflusst und die Geschwindigkeit massgeblich mitbestimmt.
Doch was, wenn der Schlüssel zur Beschleunigung nicht in der Optimierung einzelner Prozessschritte liegt, sondern im reibungslosen Zusammenspiel aller Akteure? Dieser Artikel taucht tief in diese Schweizer Ökosystem-Logik ein. Wir analysieren die kritischen Knotenpunkte – von der klinischen Studie im Unispital über die strategische Patentierung und die Wahl des Forschungsumfelds bis hin zur Rolle spezialisierter Wirtschaftscluster.
Anstatt einen simplen Zeitstrahl zu zeichnen, entschlüsseln wir die Mechanismen, die den Schweizer Innovationsstandort so einzigartig machen. Wir beleuchten, warum bestimmte Entscheidungen zu bestimmten Zeitpunkten getroffen werden müssen und wie diese das Schicksal einer potenziell lebensrettenden Therapie besiegeln.
Dieser Artikel führt Sie durch die entscheidenden Phasen und strategischen Überlegungen, die den Weg eines neuen Medikaments in der Schweiz prägen. Der folgende Überblick zeigt die zentralen Themen, die wir analysieren werden, um ein umfassendes Bild des Schweizer Innovations-Ökosystems in der Onkologie und Medizintechnik zu zeichnen.
Sommaire : Einblicke in das Schweizer Innovations-Ökosystem für Medikamente
- Warum sind Schweizer Unispitäler so begehrt für Phase-III-Studien?
- Wie sichere ich mein Molekül weltweit ab, bevor ich es publiziere?
- Sicherer Konzernjob oder Aktienoptionen im Startup: Wo forscht es sich freier?
- Das Risiko für das Image, wenn Tierversuche öffentlich kritisiert werden
- Wie schreibe ich einen SNF-Antrag, der nicht in der ersten Runde aussortiert wird?
- Warum siedeln sich MedTech-Firmen im „Medical Valley“ rund um Solothurn an?
- Warum schaffen es ETH-Erfindungen so schnell zur Marktreife?
- Wie revolutionieren Schweizer Hörgeräte und Implantate den weltweiten Gesundheitsmarkt?
Warum sind Schweizer Unispitäler so begehrt für Phase-III-Studien?
Die Phase-III-Studie ist die letzte und entscheidende Hürde vor der Zulassung eines Medikaments. Hier wird der neue Wirkstoff an einer grossen Patientengruppe auf Wirksamkeit und Sicherheit im Vergleich zum etablierten Standard getestet. Schweizer Universitätsspitäler geniessen in diesem Bereich einen exzellenten internationalen Ruf, was sie zu bevorzugten Partnern für globale Pharmakonzerne macht. Der Grund liegt in einer Kombination aus hoher Patientendichte, exzellent ausgebildetem Fachpersonal und einer herausragenden Forschungsinfrastruktur.
Die Schweizerische Arbeitsgemeinschaft für Klinische Krebsforschung (SAKK) spielt dabei eine zentrale Rolle. Als Non-Profit-Organisation koordiniert sie multizentrische, akademische Krebsstudien im ganzen Land. Das Swiss Cancer Institute führt jährlich über 70 klinische Studien in der Onkologie durch. Diese Studien laufen an zahlreichen renommierten Zentren wie dem Universitätsspital Basel, dem Inselspital Bern oder dem Kantonsspital St. Gallen und gewährleisten so den Zugang zu einer diversen Patientenpopulation unter Einhaltung höchster Qualitätsstandards.

Diese zentralisierte Koordination durch Institutionen wie die SAKK, gepaart mit der dezentralen Durchführung an Spitzenkliniken, schafft eine einzigartige Effizienz. Für Pharmaunternehmen bedeutet dies schnellere Rekrutierungszeiten, verlässliche Daten und die Zusammenarbeit mit weltweit führenden Onkologen. Für Schweizer Patienten bietet es die Chance auf einen frühen Zugang zu den innovativsten Therapien – oft Jahre vor der offiziellen Markteinführung. Diese Symbiose macht die Schweizer Spitallandschaft zu einem kritischen Beschleuniger im letzten, entscheidenden Abschnitt der Medikamentenentwicklung.
Wie sichere ich mein Molekül weltweit ab, bevor ich es publiziere?
Lange bevor eine klinische Studie überhaupt denkbar ist, steht eine der wichtigsten strategischen Weichenstellungen an: die Sicherung des geistigen Eigentums. Eine bahnbrechende Entdeckung ist wirtschaftlich wertlos, wenn sie nicht durch Patente geschützt ist. Die oberste Regel lautet: Erst anmelden, dann publizieren. Jede Veröffentlichung vor der Patentanmeldung, sei es in einem wissenschaftlichen Journal, auf einer Konferenz oder sogar in einer Dissertation, gilt als „Stand der Technik“ und kann eine spätere Patentierung weltweit zunichtemachen.
Der Prozess beginnt in der Schweiz typischerweise mit einer nationalen Prioritätsanmeldung beim Eidgenössischen Institut für Geistiges Eigentum (IGE) in Bern. Dieser Schritt sichert ein Anmeldedatum („Prioritätsdatum“), das für 12 Monate weltweit gültig ist. In diesem Zeitfenster können Forscher und ihre Institutionen – oft mit Unterstützung der universitären Technology Transfer Offices (TTOs) – weitere Daten sammeln und die kommerzielle Strategie entwickeln, ohne den Schutz zu gefährden. Innerhalb dieser 12 Monate muss dann eine internationale Nachanmeldung, meist über das Patentzusammenarbeitsvertrag-System (PCT), erfolgen, um den Schutz auf die wichtigsten Zielmärkte (USA, EU, Japan etc.) auszudehnen.
Diese rechtzeitige Absicherung ist das Fundament für alle weiteren Schritte. Sie ist die Voraussetzung, um Investoren anzuziehen, Lizenzverträge mit etablierten Pharmafirmen auszuhandeln oder ein eigenes Startup zu gründen. Ohne Patentschutz fliesst kein Risikokapital, denn nur das zeitlich begrenzte Monopol rechtfertigt die enormen Entwicklungskosten und Risiken. Die strategische Planung des Patentschutzes ist somit der erste, unverzichtbare Schritt, um aus einer wissenschaftlichen Entdeckung ein potenzielles Medikament zu machen.
Ihr Plan zur weltweiten Patentsicherung: Der Schweizer Weg
- Nationale Prioritätsanmeldung: Reichen Sie den Erstantrag beim Eidgenössischen Institut für Geistiges Eigentum (IGE) in Bern ein, um das Prioritätsdatum zu sichern.
- Beratung durch TTOs: Konsultieren Sie die Technology Transfer Offices (TTOs) Ihrer Universität für eine proaktive strategische Beratung zur Patentierbarkeit und kommerziellen Verwertung.
- Internationale PCT-Anmeldung: Führen Sie innerhalb von 12 Monaten nach dem Prioritätsdatum die internationale PCT-Anmeldung durch, um den Patentschutz global zu verfolgen.
- Nationale Phasen: Treffen Sie innerhalb von 30 Monaten nach Priorität die Entscheidung, in welchen spezifischen Ländern oder Regionen (z.B. USA, Europa, Japan) Sie in die teurere nationale Phase eintreten wollen.
- Defensive Publikation: Evaluieren Sie eine defensive Publikationsstrategie für jene Aspekte Ihrer Forschung, die nicht patentierbar sind, um zu verhindern, dass Konkurrenten diese schützen.
Sicherer Konzernjob oder Aktienoptionen im Startup: Wo forscht es sich freier?
Ist das Molekül einmal gesichert, stellt sich für den Forscher oder das Forscherteam die nächste strategische Frage: In welchem Umfeld soll die Entwicklung vorangetrieben werden? Die Schweizer Life-Sciences-Landschaft, insbesondere die Region Basel, bietet hier zwei fundamental unterschiedliche Wege: die etablierte Welt der Pharmagiganten oder die agile, aber risikoreiche Arena der Biotech-Startups.
Die grossen Konzerne wie Roche und Novartis, die allein in der Schweiz zusammen rund 26.000 Mitarbeiter beschäftigen, bieten enorme Ressourcen, etablierte Prozesse und finanzielle Sicherheit. Die Forschung ist hier oft in globale Strategien eingebettet und auf klar definierte Krankheitsfelder fokussiert. Dies bietet Stabilität, kann aber die wissenschaftliche Freiheit einschränken. Die Forschungsrichtung wird oft vom Management und den kommerziellen Prioritäten des Konzerns bestimmt (Forschungsfokus).
Auf der anderen Seite steht das boomende Startup-Ökosystem. Hier locken wissenschaftliche Autonomie (Forschungsfreiheit), flache Hierarchien und die Aussicht auf eine signifikante finanzielle Beteiligung am Erfolg durch Aktienoptionen. Das Risiko ist jedoch ungleich höher: Die Finanzierung ist oft prekär und von Meilensteinen und weiteren Finanzierungsrunden abhängig. Das Scheitern ist eine reale Möglichkeit. Doch genau dieses Umfeld zieht Risikokapital an, wie das Beispiel der Basel Area zeigt.
Fallbeispiel: Das Kapitalisierungs-Schwungrad der Basel Area
Die Region Basel ist ein Paradebeispiel für ein funktionierendes Startup-Ökosystem. Sie zeigt, wie Erfolg neuen Erfolg generiert. Allein im Jahr 2024 konnten die von Basel Area Business & Innovation unterstützten Unternehmen eine Investitionssumme von fast 500 Millionen Franken aufbringen. Dieses Kapital fliesst direkt in die Forschung, schafft hochqualifizierte Arbeitsplätze und erhöht die Wahrscheinlichkeit für den nächsten grossen Durchbruch. Erfolgreiche „Exits“ (Verkäufe von Startups an grosse Konzerne) spülen Geld und erfahrene Gründer zurück in das Ökosystem, die wiederum die nächste Generation von Startups finanzieren und beraten – ein sich selbst verstärkendes Kapitalisierungs-Schwungrad.
Die Entscheidung zwischen Konzern und Startup ist somit keine rein persönliche Präferenz, sondern eine strategische Weichenstellung, die die Entwicklungsgeschwindigkeit und die Kontrollmöglichkeiten über das Projekt massgeblich beeinflusst. Beide Wege sind integrale Bestandteile des Schweizer Erfolgsmodells und stehen in einer symbiotischen Beziehung zueinander: Konzerne sind oft die Käufer erfolgreicher Startups, während viele Startups von ehemaligen Konzernmitarbeitern gegründet werden.
Das Risiko für das Image, wenn Tierversuche öffentlich kritisiert werden
In der präklinischen Phase, bevor ein Wirkstoff überhaupt am Menschen getestet werden darf, sind Tierversuche gesetzlich vorgeschrieben. Sie dienen dazu, die grundlegende Sicherheit und Toxizität eines Moleküls zu bewerten. Gleichzeitig ist dieses Thema gesellschaftlich äusserst sensibel und birgt für forschende Unternehmen ein erhebliches Reputationsrisiko. Eine negative öffentliche Wahrnehmung kann nicht nur das Firmenimage beschädigen, sondern auch politische und regulatorische Konsequenzen nach sich ziehen.
In der Schweiz ist die Haltung der Bevölkerung und der Politik differenziert. Im Jahr 2022 wurde die eidgenössische Volksinitiative „Ja zum Tier- und Menschenversuchsverbot“ von der Bevölkerung deutlich abgelehnt. Dieses Resultat zeigt, dass eine Mehrheit den Nutzen der medizinischen Forschung höher gewichtet als ein absolutes Verbot. Dennoch erwarten Öffentlichkeit und Behörden, dass die Forschung höchsten ethischen Standards folgt. Das in der Schweiz stark verankerte 3R-Prinzip (Replace, Reduce, Refine) ist hierbei leitend. Es verpflichtet Forscher, Tierversuche wann immer möglich durch Alternativmethoden zu ersetzen (Replace), die Anzahl der Tiere auf das absolute Minimum zu reduzieren (Reduce) und die Versuchsbedingungen so zu gestalten, dass das Leid der Tiere minimiert wird (Refine).
Schweizer Forschungsinstitutionen und Unternehmen investieren daher massiv in die Entwicklung und Anwendung von Alternativmethoden wie Organ-on-a-Chip-Technologien, Computersimulationen (In-silico-Modelle) und komplexe Zellkulturen. Dieser proaktive Ansatz ist nicht nur ethisch geboten, sondern auch eine strategische Notwendigkeit. Er dient dazu, die gesellschaftliche Akzeptanz für die Forschung (social license to operate) zu erhalten und gleichzeitig wissenschaftlich validere, weil auf den Menschen übertragbarere, Ergebnisse zu erzielen. Die transparente Kommunikation über die Notwendigkeit von Tierversuchen und das gleichzeitige Engagement für das 3R-Prinzip sind entscheidend, um das Reputationsrisiko in diesem heiklen Bereich zu managen.
Wie schreibe ich einen SNF-Antrag, der nicht in der ersten Runde aussortiert wird?
Die frühe, akademische Forschung, aus der die meisten revolutionären Ideen für neue Medikamente stammen, ist auf öffentliche Gelder angewiesen. In der Schweiz ist der Schweizerische Nationalfonds (SNF) die mit Abstand wichtigste Institution für die Finanzierung der Grundlagenforschung. Einen erfolgreichen SNF-Antrag zu stellen, ist jedoch hochkompetitiv und eine Kunst für sich. Es ist eine weitere kritische Weichenstellung, die darüber entscheidet, ob eine vielversprechende Idee überhaupt die Chance bekommt, zu reifen.
Angesichts des enormen Wettbewerbs – der SNF investierte allein 2024 rund 960 Millionen CHF in über 1.800 neue Projekte – werden Anträge, die formale oder strategische Schwächen aufweisen, oft früh aussortiert. Die Gutachter achten nicht nur auf die wissenschaftliche Exzellenz und Originalität der Idee, sondern auf ein überzeugendes Gesamtpaket. Ein erfolgreicher Antrag muss mehrere Kriterien erfüllen:
- Kohärenz und Vernetzung: Das Forschungsteam muss über die nachgewiesene Expertise verfügen. Internationale Kollaborationen werden als grosses Plus gewertet, da sie den Horizont erweitern und die Robustheit der Forschung stärken.
- Datenmanagement: Ein überzeugender Data Management Plan (DMP) ist Pflicht. Er muss darlegen, wie die Forschungsdaten nach den FAIR-Prinzipien (Findable, Accessible, Interoperable, Reusable) verwaltet werden. Die Nutzung von Schweizer Infrastrukturen wie SWITCHdrive oder SWISSUbase wird positiv bewertet.
- Gesellschaftlicher und wirtschaftlicher Nutzen: Die reine Neugier genügt nicht mehr. Die „Impact“-Sektion muss konkret aufzeigen, welchen potenziellen Nutzen das Projekt für die Schweizer Gesellschaft und Wirtschaft hat, selbst wenn dieser erst langfristig zu erwarten ist.
- Open Science: Die Bereitschaft, Forschungsergebnisse und Daten offen zugänglich zu machen (Open Access, Open Data), ist zu einem zentralen Bewertungskriterium geworden.
Ein erfolgreicher SNF-Antrag ist somit mehr als nur eine brillante Idee. Er ist ein strategisches Dokument, das wissenschaftliche Vision, methodische Sorgfalt und ein klares Verständnis für die Erwartungen des Fördermittelgebers vereint. Die Fähigkeit, diese Anträge zu verfassen, ist eine Schlüsselkompetenz im Schweizer Forschungsökosystem und oft der erste Schritt, um aus Grundlagenforschung eine anwendbare Innovation zu machen.
Warum siedeln sich MedTech-Firmen im „Medical Valley“ rund um Solothurn an?
Während die Pharmaindustrie stark in Basel konzentriert ist, wo sie gemäss dem Statistischen Amt des Kantons Basel-Stadt beeindruckende 44,9% der kantonalen Wertschöpfung ausmacht, hat sich in der Schweiz eine weitere, hochspezialisierte Cluster-Logik entwickelt. Ein herausragendes Beispiel ist das „Medical Valley“ in der Region Solothurn-Bern. Hier siedeln sich nicht primär Pharma-, sondern Medizintechnik-Unternehmen an, die auf Präzisionsmechanik, Implantate und chirurgische Instrumente spezialisiert sind.
Diese Standortwahl ist kein Zufall, sondern das Ergebnis einer historischen Entwicklung und gezielter Wirtschaftsförderung. Die Region hat ihre Wurzeln in der Uhrenindustrie und verfügt daher über ein einzigartiges Reservoir an Know-how in der Mikromechanik, Materialwissenschaft und Präzisionsfertigung. Dieses Wissen ist direkt auf die Herstellung von komplexen medizinischen Geräten wie Gelenkprothesen, Dentalimplantaten oder chirurgischen Robotern übertragbar. Unternehmen finden hier ein Ökosystem aus hochqualifizierten Fachkräften, spezialisierten Zulieferern und Ausbildungsstätten, das in dieser Dichte weltweit einzigartig ist.
Im Gegensatz zum pharma- und biotech-getriebenen Wertschöpfungs-Cluster in Basel, der von Molekularbiologie und grossen Kapitalflüssen geprägt ist, basiert die Stärke des Medical Valley auf ingenieurtechnischer Exzellenz. Dies zeigt, dass das Schweizer Erfolgsmodell nicht monolithisch ist. Es besteht aus mehreren, komplementären Clustern, die jeweils auf unterschiedlichen historischen Stärken und Kompetenzen aufbauen. Diese Spezialisierung ermöglicht es auch kleineren Regionen, in globalen Nischen eine Spitzenposition einzunehmen und zur Diversität und Resilienz des gesamten Schweizer Innovationsstandorts beizutragen.
Die Logik ist dieselbe wie in Basel: Die Konzentration von Talent, Wissen und spezialisierten Dienstleistungen an einem Ort schafft einen sich selbst verstärkenden Kreislauf, der Innovation beschleunigt und es Unternehmen ermöglicht, schneller und effizienter zur Marktreife zu gelangen. Das Medical Valley ist der Beweis, dass die Ökosystem-Logik auch jenseits der grossen Pharmakonzerne funktioniert.
Warum schaffen es ETH-Erfindungen so schnell zur Marktreife?
Die akademische Forschung ist der Ursprung der meisten disruptiven Innovationen. Doch eine Erfindung allein ist noch kein Produkt. Der Weg von der Entdeckung zur Anwendung ist steinig, und die überwältigende Mehrheit der Ideen versandet. So liegt die Erfolgsquote für Krebsmedikamente bei nur etwa 7 Prozent; 93 Prozent der vielversprechenden Wirkstoffe schaffen es nie bis zum Patienten. Vor diesem Hintergrund ist die Effizienz, mit der Institutionen wie die ETH Zürich ihre Erfindungen zur Marktreife führen, bemerkenswert.
Der Schlüssel liegt in einer hochprofessionellen und proaktiven Technologietransfer-Strategie. Die Abteilung ETH transfer agiert als Brücke zwischen Wissenschaft und Wirtschaft. Sie identifiziert frühzeitig kommerziell vielversprechende Forschungsergebnisse, berät Wissenschaftler bei Patentanmeldungen und verhandelt Lizenzverträge mit der Industrie. Vor allem aber fördert sie aktiv die Gründung von Spin-off-Unternehmen. Die ETH schafft ein extrem gründerfreundliches Umfeld mit Infrastruktur, Coaching und Zugang zu einem Netzwerk von Investoren.
Diese institutionalisierte Unterstützung senkt die Hürden für Wissenschaftler, den Schritt ins Unternehmertum zu wagen. Anstatt ihre Erfindung an einen grossen Konzern zu lizenzieren, wo sie möglicherweise in einer Schublade verschwindet, können sie die Entwicklung in einem agilen Spin-off selbst vorantreiben. Dieser direkte Weg von der Forschung in ein dediziertes Unternehmen ist oft der schnellste Weg zur Marktreife. Wie Prof. Dr. Martin A. Walter von der Hirslanden Klinik St. Anna in einer Publikation in Nature Communications hervorhebt, ist Geschwindigkeit in neuen Feldern entscheidend:
Der Bereich der Theranostika entwickelt sich derzeit mit hoher Geschwindigkeit. Erstmals wird derjenige Teil des menschlichen Erbguts beschrieben, der sich mit theranostischen Arzneimitteln anvisieren lässt und der ein hohes Potenzial für die Entwicklung neuer Krebsmedikamente bietet.
– Prof. Dr. Martin A. Walter, Nature Communications, Hirslanden Klinik St. Anna
Die ETH fungiert somit nicht nur als Wissensquelle, sondern als aktive Geburtshelferin für neue Hightech-Unternehmen. Diese enge Verzahnung von Spitzenforschung und unternehmerischer Förderung ist ein Kernpfeiler des Schweizer Innovationsökosystems und ein entscheidender Faktor für die hohe Geschwindigkeit, mit der hier aus Ideen marktfähige Produkte werden.
Das Wichtigste in Kürze
- Die Geschwindigkeit der Medikamentenentwicklung in der Schweiz ist kein linearer Prozess, sondern das Ergebnis eines dynamischen Ökosystems aus Forschung, Industrie und Kapital.
- Strategische Weichenstellungen wie die frühzeitige Patentierung, die Wahl des Forschungsumfelds und die erfolgreiche Beantragung von Fördermitteln sind entscheidender als ein starrer Zeitplan.
- Spezialisierte Cluster (Pharma in Basel, MedTech in Solothurn) und effizienter Technologietransfer (ETH) sind die Motoren, die Innovationen beschleunigen und zur Marktreife bringen.
Wie revolutionieren Schweizer Hörgeräte und Implantate den weltweiten Gesundheitsmarkt?
Der Erfolg des Schweizer Innovationsökosystems beschränkt sich nicht auf die Pharmaindustrie. Der Medizintechnik-Sektor, insbesondere in den Bereichen Hörgeräte und Implantate, ist ein weiteres Paradebeispiel für globale Marktführerschaft, die aus der einzigartigen Schweizer Mischung aus Präzisionstechnik, Forschung und Kapital entsteht. Unternehmen wie Sonova (Phonak) oder Cochlear (mit starker Präsenz in Basel) dominieren ihre jeweiligen Weltmärkte.
Dieser Erfolg fusst auf denselben Prinzipien wie in der Pharmaindustrie: eine hohe Dichte an spezialisiertem Wissen, die Nähe zu exzellenten Forschungseinrichtungen und ein investitionsfreundliches Klima. Die Schweizer Biotech-Branche, die oft eng mit der Medizintechnik verknüpft ist, zeigt eine beeindruckende finanzielle Dynamik. Laut aktuellen Branchenzahlen erhielten Schweizer Biotech-Unternehmen im Jahr 2024 mit 2,5 Milliarden Schweizer Franken rund 22 Prozent mehr Investitionen als im Vorjahr. Dieses Kapital fliesst in die Entwicklung der nächsten Generation von „smarten“ Implantaten, vernetzten Hörgeräten und personalisierten medizintechnischen Lösungen.
Die Revolution liegt in der Konvergenz von Miniaturisierung, Sensorik und künstlicher Intelligenz. Moderne Schweizer Hörsysteme sind keine simplen Verstärker mehr, sondern Hochleistungscomputer, die sich in Echtzeit an die Hörumgebung anpassen, Sprache von Lärm unterscheiden und sich nahtlos mit anderen Geräten verbinden. Diese Innovationskraft ist das direkte Resultat des Ökosystems: Ingenieure aus der Uhrenindustrie liefern das Know-how für die Miniaturisierung, Forscher der ETH und EPFL entwickeln die Algorithmen, und die Universitätsspitäler liefern die klinischen Daten und den Zugang zu Patienten für die Validierung. Die Schweiz exportiert somit nicht nur Produkte, sondern einen ganzheitlichen Ansatz für die Verbesserung der Lebensqualität.
Zusammenfassend lässt sich sagen, dass der Weg eines Medikaments oder eines Medizinprodukts von der Idee zum Patienten in der Schweiz ein komplexer Tanz zwischen Wissenschaft, Strategie und Kapital ist. Die Geschwindigkeit wird nicht durch das Abarbeiten einer Checkliste bestimmt, sondern durch die Fähigkeit, an jeder strategischen Weggabelung die richtige Entscheidung zu treffen und die Synergien des einzigartigen Schweizer Ökosystems optimal zu nutzen. Für Investoren und Patienten bedeutet dies, den Fokus von starren Zeitplänen auf die Bewertung der Qualität dieser strategischen Entscheidungen und der Positionierung innerhalb des Ökosystems zu verlagern. Um eine fundierte Einschätzung über eine spezifische Technologie oder ein Unternehmen zu erhalten, ist eine detaillierte Analyse im Kontext dieses Systems unerlässlich.